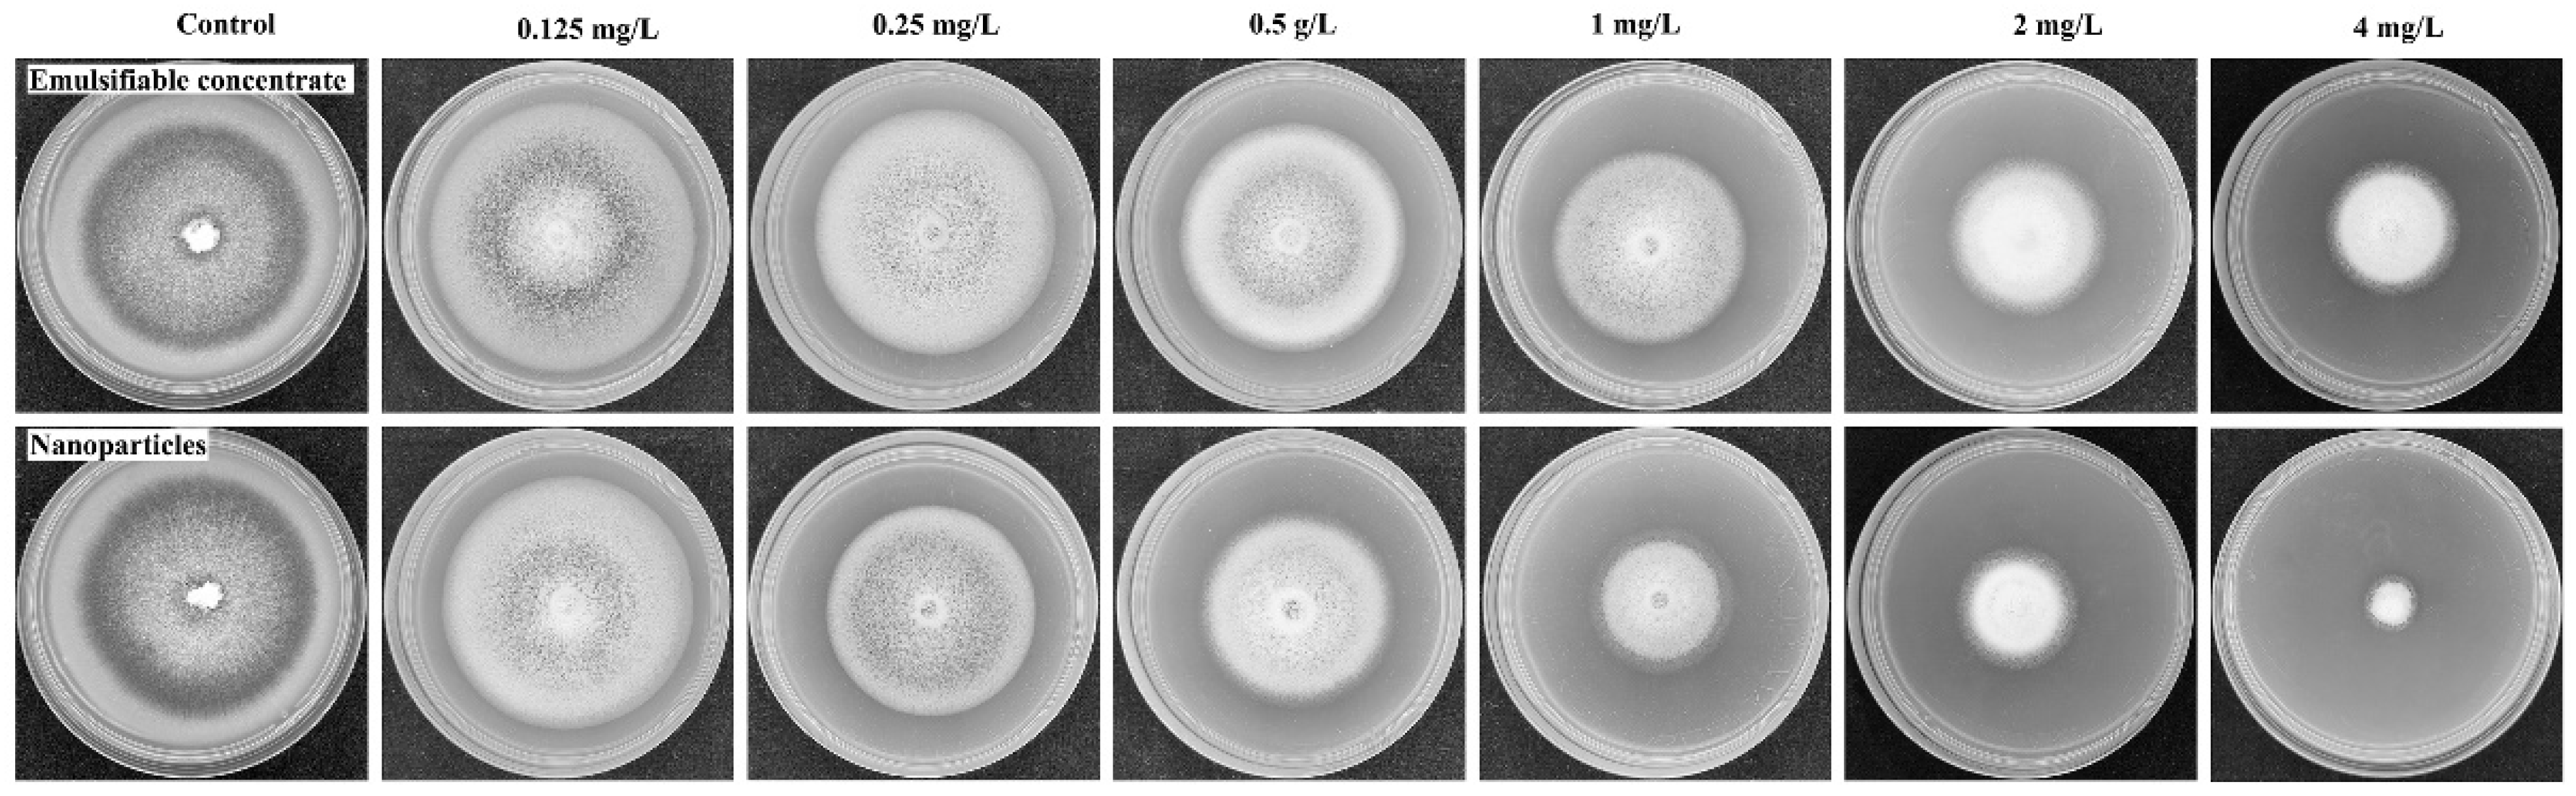
Nanomaterials 12 04249 g009

Degradable Self-Destructive Redox-Responsive System Based on Mesoporous Organosilica Nano-Vehicles for Smart Delivery of Fungicide
Abstract
1. Introduction
2. Experimental
2.1. Materials
2.2. Preparation of PRO@DMON–GA–Fe(III) Nanoparticles
2.2.1. Synthesis of Disulfide-Bridged Mesoporous Organosilica (DMON) Nanoparticles
2.2.2. Synthesis of PRO@DMON–GA–Fe(III) Nanoparticles
2.3. Characterization
2.4. Biodegradation Assays of DMON Nanoparticles
2.5. Pesticide Loading Content and Controlled Release Kinetics
2.5.1. Pesticide Loading Content
2.5.2. Controlled Release Kinetics
2.6. Photolysis Test
2.7. Spreadability of PRO@DMON–GA–Fe(III) Nanoparticles on Rice Blades
2.8. Fungicidal Activity
2.9. Safety Assay
2.10. Data Analysis
3. Results and Discussion
3.1. Preparation and Characterization of PRO@DMON–GA–Fe(III) Nanoparticles
3.2. Reducibility-Responsive Biodegradability Assay
3.3. Pesticide Loading and Controlled Release Kinetics
3.4. Photostability of the PRO@DMON–GA–Fe(III) Nanoparticles
3.5. Spreadability of DMON-GA-Fe(III) Nanoparticles on Rice Blades
3.6. Bioactivity
3.7. Safety of DMON–GA–Fe(III) Nanoparticles on Rice Seedlings
4. Conclusions
Author Contributions
Funding
Data Availability Statement
Conflicts of Interest
References
- Wang, D.; Saleh, N.B.; Byro, A.; Zepp, R.; Sahle-Demessie, E.; Luxton, T.P.; Ho, K.T.; Burgess, R.M.; Flury, M.; White, J.C.; et al. Nano-enabled pesticides for sustainable agriculture and global food security. Nat. Nanotechnol. 2022, 17, 347–360. [Google Scholar] [CrossRef]
- Bhatt, D.; Srivastava, A.; Srivastava, P.C.; Sharma, A. Evaluation of three novel soil bacterial strains for efficient biodegradation of persistent boscalid fungicide: Kinetics and identification of microbial biodegradation intermediates. Environ. Pollut. 2023, 316, 120484. [Google Scholar] [CrossRef]
- Wang, X.; Yan, M.; Zhou, J.; Song, W.; Xiao, Y.; Cui, C.; Gao, W.; Ke, F.; Zhu, J.; Gu, Z. Delivery of acetamiprid to tea leaves enabled by porous silica nanoparticles: Efficiency, distribution and metabolism of acetamiprid in tea plants. BMC Plant Biol. 2021, 21, 337. [Google Scholar] [CrossRef] [PubMed]
- Foong, S.Y.; Ma, N.L.; Lam, S.S.; Peng, W.; Low, F.; Lee, B.H.K.; Alstrup, A.K.O.; Sonne, C. A recent global review of hazardous chlorpyrifos pesticide in fruit and vegetables: Prevalence, remediation and actions needed. J. Hazard. Mater. 2020, 400, 123006. [Google Scholar] [CrossRef] [PubMed]
- Singh, G.; Ramadass, K.; Sooriyakumar, P.; Hettithanthri, O.; Vithange, M.; Bolan, N.; Tavakkoli, E.; van Zwieten, L.; Vinu, A. Nanoporous materials for pesticide formulation and delivery in the agricultural sector. J. Control. Release 2022, 343, 187–206. [Google Scholar] [CrossRef] [PubMed]
- Kumar, S.; Nehra, M.; Dilbaghi, N.; Marrazza, G.; Hassan, A.A.; Kim, K.-H. Nano-based smart pesticide formulations: Emerging opportunities for agriculture. J. Control. Release 2019, 294, 131–153. [Google Scholar] [CrossRef]
- Singh, A.; Dhiman, N.; Kar, A.K.; Singh, D.; Purohit, M.P.; Ghosh, D.; Patnaik, S. Advances in controlled release pesticide formulations: Prospects to safer integrated pest management and sustainable agriculture. J. Hazard. Mater. 2020, 385, 121525. [Google Scholar] [CrossRef]
- Liu, T.; Luo, J.; Liu, S.; Li, T.; Li, H.; Zhang, L.; Mu, W.; Zou, N. Clothianidin loaded TA/Fe (III) controlled-release granules: Improve pesticide bioavailability and alleviate oxidative stress. J. Hazard. Mater. 2021, 416, 125861. [Google Scholar] [CrossRef]
- Hedaoo, R.K.; Gite, V.V. Renewable resource-based polymeric microencapsulation of natural pesticide and its release study: An alternative green approach. RSC Adv. 2014, 4, 18637–18644. [Google Scholar] [CrossRef]
- Zeng, X.; Zhong, B.; Jia, Z.; Zhang, Q.; Chen, Y.; Jia, D. Halloysite nanotubes as nanocarriers for plant herbicide and its controlled release in biodegradable polymers composite film. Appl. Clay Sci. 2019, 171, 20–28. [Google Scholar] [CrossRef]
- Zhang, H.; Shi, Y.; Xu, X.; Zhang, M.; Ma, L. Structure regulation of bentonite-alginate nanocomposites for controlled release of imidacloprid. ACS Omega 2020, 5, 10068–10076. [Google Scholar] [CrossRef] [PubMed]
- Riseh, R.S.; Hassanisaadi, M.; Vatankhah, M.; Soroush, F.; Varma, R.S. Nano/microencapsulation of plant biocontrol agents by chitosan, alginate, and other important biopolymers as a novel strategy for alleviating plant biotic stresses. Int. J. Biol. Macromol. 2022, 222, 1589–1604. [Google Scholar] [CrossRef] [PubMed]
- Hofmann, T.; Lowry, G.V.; Ghoshal, S.; Tufenkji, N.; Brambilla, D.; Dutcher, J.R.; Gilbertson, L.M.; Giraldo, J.P.; Kinsella, J.M.; Landry, M.P.; et al. Technology readiness and overcoming barriers to sustainably implement nanotechnology-enabled plant agriculture. Nat. Food 2020, 1, 416–425. [Google Scholar] [CrossRef]
- Camara, M.C.; Monteiro, R.A.; Carvalho, L.B.; Oliveira, J.L.; Fraceto, L.F. Enzyme stimuli–responsive nanoparticles for bioinsecticides: An emerging approach for uses in crop protection. ACS Sustain. Chem. Eng. 2021, 9, 106–112. [Google Scholar] [CrossRef]
- Monteiro, R.A.; Camara, M.C.; de Oliveira, J.L.; Campos, E.V.R.; Carvalho, L.B.; Proença, P.L.d.F.; Guilger-Casagrande, M.; Lima, R.; Nascimento, J.d.; Gonçalves, K.C.; et al. Zein based-nanoparticles loaded botanical pesticides in pest control: An enzyme stimuli-responsive approach aiming sustainable agriculture. J. Hazard. Mater. 2021, 417, 126004. [Google Scholar] [CrossRef]
- Zhao, M.; Li, P.; Zhou, H.; Hao, L.; Chen, H.; Zhou, X. pH/redox dual responsive from natural polymer-based nanoparticles for on-demand delivery of pesticides. Chem. Eng. J. 2022, 435, 134861. [Google Scholar] [CrossRef]
- Liang, Y.; Wang, S.; Dong, H.; Yu, S.; Jia, H.; Wang, J.; Yao, Y.; Wang, Y.; Song, J.; Huo, Z. Zeolitic imidazole framework-90-based pesticide smart-delivery system with enhanced antimicrobial performance. Nanomaterials 2022, 12, 3622. [Google Scholar] [CrossRef]
- Liang, Y.; Gao, Y.; Wang, W.; Dong, H.; Tang, R.; Yang, J.; Niu, J.; Zhou, Z.; Jiang, N.; Cao, Y. Fabrication of smart stimuli-responsive mesoporous organosilica nano-vehicles for targeted pesticide delivery. J. Hazard. Mater. 2020, 389, 122075. [Google Scholar] [CrossRef]
- Guan, M.; Li, Z.; Hao, L.; Zhou, M.; Chen, L.; Chen, H.; Zhou, H.; Zhou, X. Functionalization of boron nitride nanosheets via thiol terminated polyethyleneimine to enhance aqueous dispersibility and efficiency as carriers for essential oils and pesticides. Chem. Eng. J. 2021, 423, 130166. [Google Scholar] [CrossRef]
- Zhao, M.; Chen, Z.; Hao, L.; Chen, H.; Zhou, X.; Zhou, H. CMC based microcapsules for smart delivery of pesticides with reduced risks to the environment. Carbohydr. Polym. 2023, 300, 120260. [Google Scholar] [CrossRef]
- Liang, W.; Xie, Z.; Cheng, J.; Xiao, D.; Xiong, Q.; Wang, Q.; Zhao, J.; Gui, W. A light-triggered pH-responsive metal–organic framework for smart delivery of fungicide to control Sclerotinia diseases of oilseed rape. ACS Nano 2021, 15, 6987–6997. [Google Scholar] [CrossRef]
- Zhang, L.; Chen, C.; Zhang, J.; Liu, B.; Teng, G.; Wang, J.; Zhang, X.; Cai, D.; Wu, Z. Alternating magnetic field-responsive nanoplatforms for controlled imidacloprid release and sustainable pest control. ACS Sustain. Chem. Eng. 2021, 9, 10491–10502. [Google Scholar] [CrossRef]
- Li, X.; Han, J.; Wang, X.; Zhang, Y.; Jia, C.; Qin, J.; Wang, C.; Wu, J.; Fang, W.; Yang, Y. A triple-stimuli responsive hormone delivery system equipped with pillararene magnetic nanovalves. Mater. Chem. Front. 2019, 3, 103–110. [Google Scholar] [CrossRef]
- Gao, Y.; Liang, Y.; Dong, H.; Niu, J.; Tang, J.; Yang, J.; Tang, G.; Zhou, Z.; Tang, R.; Shi, X.; et al. A bioresponsive system based on mesoporous organosilica nanoparticles for smart delivery of fungicide in response to pathogen presence. ACS Sustain. Chem. Eng. 2020, 8, 5716–5723. [Google Scholar] [CrossRef]
- Yang, Y.; Lu, Y.; Abbaraju, P.L.; Azimi, I.; Lei, C.; Tang, J.; Jambhrunkar, M.; Fu, J.; Zhang, M.; Liu, Y.; et al. Stepwise degradable nanocarriers enabled cascade delivery for synergistic cancer therapy. Adv. Funct. Mater. 2018, 28, 1800706. [Google Scholar] [CrossRef]
- Yang, Y.; Sun, W. Recent advances in redox-responsive nanoparticles for combined cancer therapy. Nanoscale Adv. 2022, 4, 3504–3516. [Google Scholar] [CrossRef] [PubMed]
- Bai, J.; Zhang, Y.; Tang, C.; Hou, Y.; Ai, X.; Chen, X.; Zhang, Y.; Wang, X.; Meng, X. Gallic acid: Pharmacological activities and molecular mechanisms involved in inflammation-related diseases. Biomed. Pharmacother. 2021, 133, 110985. [Google Scholar] [CrossRef] [PubMed]
- Zhang, H.; Montemayor, A.M.; Wimsatt, S.T.; Tikekar, R.V. Effect of combination of UV-A light and chitosan-gallic acid coating on microbial safety and quality of fresh strawberries. Food Control. 2022, 140, 109106. [Google Scholar] [CrossRef]
- El-Nagar, A.; Elzaawely, A.A.; Taha, N.A.; Nehela, Y. The antifungal activity of gallic acid and its derivatives against Alternaria solani, the causal agent of tomato early blight. Agronomy 2020, 10, 1402. [Google Scholar] [CrossRef]
- Luzi, F.; Puglia, D.; Dominici, F.; Fortunati, E.; Giovanale, G.; Balestra, G.M.; Torre, L. Effect of gallic acid and umbelliferone on thermal, mechanical, antioxidant and antimicrobial properties of poly (vinyl alcohol-co-ethylene) films. Polym. Degrad. Stab. 2018, 152, 162–176. [Google Scholar] [CrossRef]
- Cherepanov, P.V.; Rahim, M.A.; Bertleff-Zieschang, N.; Sayeed, M.A.; O’Mullane, A.P.; Moulton, S.E.; Caruso, F. Electrochemical behavior and redox-dependent disassembly of gallic acid/FeIII metal–phenolic networks. ACS Appl. Mater. Interfaces 2018, 10, 5828–5834. [Google Scholar] [CrossRef] [PubMed]
- Maerten, C.; Lopez, L.; Lupattelli, P.; Rydzek, G.; Pronkin, S.; Schaaf, P.; Jierry, L.; Boulmedais, F. Electrotriggered confined self-assembly of metal–polyphenol nanocoatings using a morphogenic approach. Chem. Mater. 2017, 29, 9668–9679. [Google Scholar] [CrossRef]
- Fan, G.; Cottet, J.; Rodriguez-Otero, M.R.; Wasuwanich, P.; Furst, A.L. Metal–phenolic networks as versatile coating materials for biomedical applications. ACS Appl. Bio Mater. 2022, 5, 4687–4695. [Google Scholar] [CrossRef] [PubMed]
- Liu, C.; Li, C.; Jiang, S.; Zhang, C.; Tian, Y. pH-responsive hollow Fe–gallic acid coordination polymer for multimodal synergistic-therapy and MRI of cancer. Nanoscale Adv. 2022, 4, 173–181. [Google Scholar] [CrossRef] [PubMed]
- Shah, S.T.; Yehya, W.A.; Saad, O.; Simarani, K.; Chowdhury, Z.; Alhadi, A.A.; Al-Ani, L.A. Surface functionalization of iron oxide nanoparticles with gallic acid as potential antioxidant and antimicrobial agents. Nanomaterials 2017, 7, 306. [Google Scholar] [CrossRef] [PubMed]
- Han, Y.; Dong, Z.; Wang, C.; Li, Q.; Hao, Y.; Yang, Z.; Zhu, W.; Zhang, Y.; Liu, Z.; Feng, L. Ferrous ions doped calcium carbonate nanoparticles potentiate chemotherapy by inducing ferroptosis. J. Control. Release 2022, 348, 346–356. [Google Scholar] [CrossRef]
- Guo, J.; Suma, T.; Richardson, J.J.; Ejima, H. Modular assembly of biomaterials using polyphenols as building blocks. ACS Biomater. Sci. Eng. 2019, 5, 5578–5596. [Google Scholar] [CrossRef]
- Gindri, R.G.; Navarro, B.B.; Dias, P.V.d.; Tarouco, C.P.; Nicoloso, F.T.; Brunetto, G.; Berghetti, Á.L.P.; da Silva, L.O.S.; Fett, J.P.; Menguer, P.K.; et al. Physiological responses of rice (Oryza sativa L.) oszip7 loss-of-function plants exposed to varying Zn concentrations. Physiol. Mol. Biol. Plants 2020, 26, 1349–1359. [Google Scholar] [CrossRef]
- Fernandez, J.; Orth, K. Rise of a cereal killer: The biology of Magnaporthe oryzae biotrophic growth. Trends Microbiol. 2018, 26, 582–597. [Google Scholar] [CrossRef]
- Salman, E.K.; Ghoniem, K.E.; Badr, E.S.; Emeran, A.A. The potential of dimetindene maleate inducing resistance to blast fungus Magnaporthe oryzae through activating the salicylic acid signaling pathway in rice plants. Pest Manag. Sci. 2022, 78, 633–642. [Google Scholar] [CrossRef]
- Samalova, M.; Meyer, A.J.; Gurr, S.J.; Fricker, M.D. Robust anti-oxidant defences in the rice blast fungus Magnaporthe oryzae confer tolerance to the host oxidative burst. New Phytol. 2014, 201, 556–573. [Google Scholar] [CrossRef] [PubMed]
- Hayashi, K.; Fujita, Y.; Ashizawa, T.; Suzuki, F.; Nagamura, Y.; Hayano-Saito, Y. Serotonin attenuates biotic stress and leads to lesion browning caused by a hypersensitive response to Magnaporthe oryzae penetration in rice. Plant J. 2016, 85, 46–56. [Google Scholar] [CrossRef] [PubMed]
- Xu, C.; Ban, Q.; Wang, W.; Hou, J.; Jiang, Z. Novel nano-encapsulated probiotic agents: Encapsulate materials, delivery, and encapsulation systems. J. Control. Release 2022, 349, 184–205. [Google Scholar] [CrossRef] [PubMed]
- Wang, C.-Y.; Lou, X.-Y.; Cai, Z.; Zhang, M.-Z.; Jia, C.; Qin, J.-C.; Yang, Y.-W. Supramolecular nanoplatform based on mesoporous silica nanocarriers and pillararene nanogates for fungus control. ACS Appl. Mater. Interfaces 2021, 13, 32295–32306. [Google Scholar] [CrossRef]
- Xiao, D.; Cheng, J.; Liang, W.; Sun, L.; Zhao, J. Metal-phenolic coated and prochloraz-loaded calcium carbonate carriers with pH responsiveness for environmentally-safe fungicide delivery. Chem. Eng. J. 2021, 418, 129274. [Google Scholar] [CrossRef]
- Zhang, Y.; Zhang, B.; Luo, C.; Fu, Y.; Zhu, F. Fungicidal actions and resistance mechanisms of prochloraz to Penicillium digitatum. Plant Dis. 2021, 105, 408–415. [Google Scholar] [CrossRef]
- Wang, C.; Xu, L.; Liang, X.; Zhang, Y.; Zheng, H.; Chen, J.; Yang, Y. Biochemical and molecular characterization of prochloraz resistance in Lasiodiplodia theobromae field isolates. Plant Dis. 2022. [Google Scholar] [CrossRef]
- Wu, L.; Pan, H.; Huang, W.; Wang, M.; Hu, Z.; Zhang, F. Self-assembled degradable iron-doped mesoporous silica nanoparticles for the smart delivery of prochloraz to improve plant protection and reduce environmental impact. Environ. Technol. Innov. 2022, 28, 102890. [Google Scholar] [CrossRef]
- Gao, X.; Peng, Q.; Yuan, K.; Li, Y.; Shi, M.; Miao, J.; Liu, X. Monitoring and characterization of prochloraz resistance in Fusarium fujikuroi in China. Pestic. Biochem. Physiol. 2022, 187, 105189. [Google Scholar] [CrossRef]
- Abdelrahman, T.M.; Qin, X.; Li, D.; Senosy, I.A.; Mmby, M.; Wan, H.; Li, J.; He, S. Pectinase-responsive carriers based on mesoporous silica nanoparticles for improving the translocation and fungicidal activity of prochloraz in rice plants. Chem. Eng. J. 2021, 404, 126440. [Google Scholar] [CrossRef]
- Liang, Y.; Fan, C.; Dong, H.; Zhang, W.; Tang, G.; Yang, J.; Jiang, N.; Cao, Y. Preparation of MSNs-chitosan@prochloraz nanoparticles for reducing toxicity and improving release properties of prochloraz. ACS Sustain. Chem. Eng. 2018, 6, 10211–10220. [Google Scholar] [CrossRef]
- Chen, Z.; Wang, X.; Shi, L.; Liu, Q.; Gao, Y.; Chen, W.; Yang, J.; Yuan, X.; Feng, J. Fabrication and characterization of prochloraz nanoemulsion against Penicillium citrinum for the postharvest storage of navel oranges. Langmuir 2021, 37, 13757–13766. [Google Scholar] [CrossRef]
- Zhao, P.; Cao, L.; Ma, D.; Zhou, Z.; Huang, Q.; Pan, C. Translocation, distribution and degradation of prochloraz-loaded mesoporous silica nanoparticles in cucumber plants. Nanoscale 2018, 10, 1798–1806. [Google Scholar] [CrossRef] [PubMed]
- Tóth, I.Y.; Szekeres, M.R.; Turcu, R.; Sáringer, S.R.; Illés, E.B.; Nesztor, D.N.; Tombácz, E. Mechanism of in situ surface polymerization of gallic acid in an environmental-inspired preparation of carboxylated core–shell magnetite nanoparticles. Langmuir 2014, 30, 15451–15461. [Google Scholar] [CrossRef]
- Ossai, V.; Obiefuna, A.P.; Laraps, B.C.; Okenyeka, O.U.; Ezeorah, J.C.; Dege, N.; Ibezim, A.; Lutter, M.; Jurkschat, K.; Obasi, N.L. Crystal structural and in silico studies of Schiff bases derived from 4-aminoantipyrine. Solid State Sci. 2020, 106, 106293. [Google Scholar] [CrossRef]
- Shi, L.; Liang, Q.; Zang, Q.; Lv, Z.; Meng, X.; Feng, J. Construction of prochloraz-loaded hollow mesoporous silica nanoparticles coated with metal–phenolic networks for precise release and improved biosafety of pesticides. Nanomaterials 2022, 12, 2885. [Google Scholar] [CrossRef] [PubMed]
- Cheng, Y.; Jiao, X.; Fan, W.; Yang, Z.; Wen, Y.; Chen, X. Controllable synthesis of versatile mesoporous organosilica nanoparticles as precision cancer theranostics. Biomaterials 2020, 256, 120191. [Google Scholar] [CrossRef] [PubMed]
- Huang, L.; Feng, J.; Fan, W.; Tang, W.; Rong, X.; Liao, W.; Wei, Z.; Xu, Y.; Wu, A.; Chen, X.; et al. Intelligent pore switch of hollow mesoporous organosilica nanoparticles for high contrast magnetic resonance imaging and tumor-specific chemotherapy. Nano Lett. 2021, 21, 9551–9559. [Google Scholar] [CrossRef]
- Duan, L.; Fang, Z.; Han, X.; Dou, Z.; Liu, Y.; Wen, M.; Hou, T.; Yang, D.; Wang, C.; Zhang, G. Study on droplet impact and spreading and deposition behavior of harvest aids on cotton leaves. Langmuir 2022, 38, 12248–12262. [Google Scholar] [CrossRef]
- Zheng, D.; Bai, B.; Zhao, H.; Xu, X.; Hu, N.; Wang, H. Stimuli-responsive Ca-alginate-based photothermal system with enhanced foliar adhesion for controlled pesticide release. Colloids Surf. B 2021, 207, 112004. [Google Scholar] [CrossRef]
- Liang, Y.; Song, J.; Dong, H.; Huo, Z.; Gao, Y.; Zhou, Z.; Tian, Y.; Li, Y.; Cao, Y. Fabrication of pH-responsive nanoparticles for high efficiency pyraclostrobin delivery and reducing environmental impact. Sci. Total Environ. 2021, 787, 147422. [Google Scholar] [CrossRef] [PubMed]
- Hassanisaadi, M.; Barani, M.; Rahdar, A.; Heidary, M.; Thysiadou, A.; Kyzas, G.Z. Role of agrochemical-based nanomaterials in plants: Biotic and abiotic stress with germination improvement of seeds. Plant Growth Regul. 2022, 97, 375–418. [Google Scholar] [CrossRef]
- Hatamleh, A.A.; Danish, M.; Al-Dosary, M.A.; El-Zaidy, M.; Ali, S. Physiological and oxidative stress responses of Solanum lycopersicum (L.) (tomato) when exposed to different chemical pesticides. RSC Adv. 2022, 12, 7237–7252. [Google Scholar] [CrossRef] [PubMed]

| Sample | BET Surface Area (m2/g) | Pore Volume (cm3/g) | Average Pore Size (nm) |
|---|---|---|---|
| DMON | 1020.81 | 1.13 | 2.33 |
| PRO@DMON | 124.57 | 0.47 | 1.57 |
| PRO@DMON–GA–Fe(III) | 32.15 | - | - |
| Glutathione Concentration (mM) | Kinetic Model | K (×10−2) | n | r2 |
|---|---|---|---|---|
| 0 | Zero-order | 0.22 | — | 0.7929 |
| First-order | 0.07 | — | 0.7385 | |
| Higuchi | 2.17 | — | 0.9632 | |
| Ritger–Peppas | 3.15 | 0.42 | 0.9336 | |
| 2 | Zero-order | 0.49 | — | 0.7962 |
| First-order | 0.21 | — | 0.7563 | |
| Higuchi | 4.75 | — | 0.9646 | |
| Ritger–Peppas | 6.26 | 0.45 | 0.9385 | |
| 10 | Zero-order | 1.10 | — | 0.7744 |
| First-order | 1.44 | — | 0.9280 | |
| Higuchi | 10.72 | — | 0.9550 | |
| Ritger–Peppas | 17.46 | 0.39 | 0.9325 |
| Parameter | Pseudo-First-Order Kinetics | ||
|---|---|---|---|
| Technical | Emulsifiable Concentrate | Nanoparticles | |
| k (h−1) | 0.089 | 0.095 | 0.0044 |
| Relative index (r2) | 0.995 | 0.994 | 0.933 |
| DT50 (h) a | 7.79 | 7.37 | 154.03 |
| Treatment | Regression Equation | EC50 (95% Confidence Interval) (mg/L) | Correlation Coefficient (r2) |
|---|---|---|---|
| Prochloraz emulsifiable concentrate | y = 0.39 + 1.02x | 2.39 (2.00–2.94) | 0.991 |
| PRO@DMON–GA–Fe(III) nanoparticles | y = 0.12 + 1.31x | 0.81 (0.73–0.91) | 0.992 |
| Concentration (mg/L) | Germination Rate (%) | Root Length (cm) a | Shoot Length (cm) | Root Number | Fresh Weight (mg) |
|---|---|---|---|---|---|
| 0 | 100 | 7.94 ± 0.91 a | 5.24 ± 0.36 a | 3.54 ± 0.80 a | 39.38 ± 2.37 a |
| 50 | 100 | 8.21 ± 0.64 a | 5.03 ± 0.39 a | 4.04 ± 0.76 a | 35.00 ± 1.02 a |
| 100 | 100 | 7.46 ± 1.13 a | 4.78 ± 0.42 a | 3.45 ± 0.91 a | 35.00 ± 3.68 a |
| 200 | 100 | 7.56 ± 1.25 a | 5.16 ± 0.50 a | 3.67 ± 1.03 a | 38.13 ± 2.58 a |
| 400 | 100 | 8.13 ± 0.55 a | 4.17 ± 0.94 a | 3.83 ± 0.87 a | 39.38 ± 1.57 a |
| 800 | 100 | 7.53 ± 0.67 a | 5.09 ± 0.50 a | 3.27 ± 0.75 a | 33.75 ± 0.72 a |
Publisher’s Note: MDPI stays neutral with regard to jurisdictional claims in published maps and institutional affiliations. |
© 2022 by the authors. Licensee MDPI, Basel, Switzerland. This article is an open access article distributed under the terms and conditions of the Creative Commons Attribution (CC BY) license (https://creativecommons.org/licenses/by/4.0/).
Share and Cite
Liang, Y.; Wang, S.; Yao, Y.; Yu, S.; Li, A.; Wang, Y.; Song, J.; Huo, Z. Degradable Self-Destructive Redox-Responsive System Based on Mesoporous Organosilica Nano-Vehicles for Smart Delivery of Fungicide. Nanomaterials 2022, 12, 4249. https://doi.org/10.3390/nano12234249
Liang Y, Wang S, Yao Y, Yu S, Li A, Wang Y, Song J, Huo Z. Degradable Self-Destructive Redox-Responsive System Based on Mesoporous Organosilica Nano-Vehicles for Smart Delivery of Fungicide. Nanomaterials. 2022; 12(23):4249. https://doi.org/10.3390/nano12234249
Chicago/Turabian StyleLiang, You, Sijin Wang, Yijia Yao, Siwen Yu, Ao Li, Yuanfeng Wang, Jiehui Song, and Zhongyang Huo. 2022. "Degradable Self-Destructive Redox-Responsive System Based on Mesoporous Organosilica Nano-Vehicles for Smart Delivery of Fungicide" Nanomaterials 12, no. 23: 4249. https://doi.org/10.3390/nano12234249
APA StyleLiang, Y., Wang, S., Yao, Y., Yu, S., Li, A., Wang, Y., Song, J., & Huo, Z. (2022). Degradable Self-Destructive Redox-Responsive System Based on Mesoporous Organosilica Nano-Vehicles for Smart Delivery of Fungicide. Nanomaterials, 12(23), 4249. https://doi.org/10.3390/nano12234249

